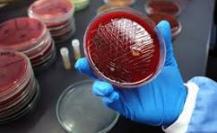
Blood culture tests

About Us
Welcome to Vitamin Veterinary Laboratory, where precision and speed of delivery meet quality healthcare. At Vitamin Veterinary Laboratory, we believe your health deserves the best. That's why we provide advanced veterinary laboratory services, supported by modern technologies and a specialized team with extensive experience. We offer free, accurate tests that aid in early diagnosis and effective treatment, and we ensure our results are reliable and capable of achieving scientific breakthroughs for both physicians and breeders. With us, rest assured... your health is in safe hands.
Services
We provide advanced veterinary medicines and health solutions to support animal well-being and productivity. Trusted by professionals for quality, safety, and innovation.

100.00

100.00

100.00

100.00
200.00

150.00

80.00

10.00

30.00

35.00
Accurate and Reliable Testing
Precise diagnostics for diseases, vitamins, and microbes with global standards.
Modern and Advanced Equipment
Latest global devices and techniques for fast, accurate results.
Regular Calibration and Maintenance
Regular calibration and maintenance of all devices are carried out to ensure accuracy and reliability
Qualified and Experienced Team
Skilled team with ongoing training in lab diagnostics and technology.
Field Transportation Service
Equipped vehicles to pick up and deliver samples anywhere.
Clear and Detailed Reports
Easy reports for better decisions, with fast results and secure data.
Devices
We provide advanced veterinary medicines and health solutions to support animal well-being and productivity. Trusted by professionals for quality, safety, and innovation.











